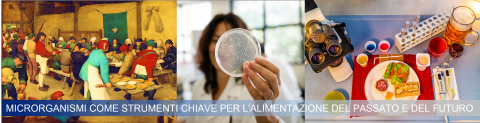
micropensiamoci

30/09/2022
19:00 - 23:00
Cesena
- Biblioteca Malatestiana
Accesso libero
Image
Andremo scoprire il mondo dei microrganismi, li osserveremo al microscopio, e vedremo il fondamentale ruolo che svolgono nelle produzioni di alimenti fermentati e il perché rappresentano un tassello chiave per un futuro più sostenibile. Sarà diffuso materiale divulgativo sui progetti ricerca in cui il gruppo è coinvolto.
A cura di Lorenzo Siroli
Destinatari
Adulti
Format
Esperimenti ed esperienze
Tematica
Tecnologie
Disciplina
Scienze Agrarie e Nutrizione
Enti
Università di Bologna Campus di Cesena
Percorso
Esplorare il presente